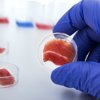

Fritextsökning
Artiklar per år
- Alla (47 818)
- 2026 (645)
- 2025 (1 414)
- 2024 (1 387)
- 2023 (1 475)
- 2022 (1 492)
- 2021 (1 381)
- 2020 (1 500)
- 2019 (1 794)
- 2018 (1 884)
- 2017 (1 557)
- 2016 (1 678)
- 2015 (1 160)
- 2014 (1 026)
- 2013 (1 376)
- 2012 (2 077)
- 2011 (2 235)
- 2010 (1 445)
- 2009 (5 748)
- 2008 (6 072)
- 2007 (3 749)
- 2006 (472)
- 2005 (134)
- 2004 (1 259)
- 2003 (2 152)
- 2002 (683)
- 2000 (247)
-

SCB: Emv ökade 22 gånger mer än ekologiskt
Att försäljningen av ekologiska livsmedel minskar samtidigt som livsmedelskedjornas egna märkesvaror ökar stort blir ännu tydligare i ett femårigt perspektiv, visar nya SCB-siffror.
-

SCB: Emv ökade 22 gånger mer än ekologiskt
Svenskarna lägger allt mindre pengar på ekologiska livsmedel. Samtidigt ökar försäljningen av livsmedelskedjornas egna märkesvaror stort, visar ny statistik från SCB.
-

Icax nya e-handelstjänst: Paketen samåker med maten
Adlibris först ut med gemensamma transporter i Icas nya pakettjänst. Näst på tur står Apotek Hjärtat.
-

Förklarar galna siffran: ”Hårt drabbade av pandemin”
Några siffror sticker ut när Fri Köpenskap granskar årsredovisningar för Maxibutikerna. Ica Maxi Haparanda ökade sin omsättning med 23,2 procent och resultatet med hela 258,2 procent. – Vi var hårt drabbade av pandemin, säger tf handlaren Frans Nordlund.
-

Magnus Winges om räkenskapsåret: Fler kunder köper färre varor
Ica Maxi Kumla utmärker sig för en kraftig omsättningsökning. Förklaringen är enkel. Handlaren Magnus Winges tog över butiken i maj 2021, så jämförelsetalen haltar.
-

Topplistorna – Maxibutikerna som är störst, ökar mest och tappar mest
Här är topplistorna över de Ica Maxibutiker som omsätter mest, tjänar mest, ökat och tappat i omsättning och vinst.
-

Resultaten för alla Maxibutiker – så mycket har Icas vinstmaskiner tappat
Ica Maxibutikerna är fortfarande vinstmaskiner, i de flesta fallen. Men Icas flaggskepp tappade fart ordentligt under 2022, visar Fri Köpenskaps sammanställning över butikernas bokslut.
-

”Dagligvarusäljaren behöver bli mer rådgivande”
Dagligvarusäljarens roll förändras när frågan blir hur varumärkena kan stötta butikens utveckling, skriver retailexperten Martin Moström i sin krönika.
-

Jättepumpan i största Coop-butiken: ”Vill ge barnen en Halloweenpresent”
– Pumpan är så stor så den gick inte in vid varuingången på baksidan. Vi fick ta in den via stora ingången, säger Lennart Martinsson, butikschef på Stora Coop i Lund.
-

Svenskt proteinbolag växlar upp mot matbutikerna
Karlskogabaserade Gaam ingår samarbete med Sales Support.
-

Robot ska sköta paketutdelningen när Ica-butiken satsar 20 miljoner
Ny pantstation och förbutik. Samt en robot som delar ut paket. Ica Kvantum Falkenberg står inför en rad uppdateringar.
-

Hela listan på alla Xtrabutiker – och så ser framtiden ut för Coops lågprissatsning
Stor intervju med Ola Andersson som lämnar Xtra för att bli affärschef för Stora Coop. Om tillväxttakten, lönsamheten, butiksdriften och framtidsplanerna.
-

Matpriskollen: Kampanjtrycket på tonfisk ökar
I veckans granskning av kedjornas kampanjer noterar Ulf Mazur på Matpriskollen framgångarna för kampanjer på fiskkonserver, och att kampanjtrycket ökat rejält på dessa.
-

Lantbrukare oroas över lönsamheten – tuffast för mjölk och växtodling
Swedbank presenterade höstens Lantbruksbarometer.
-

Livsmedelsföretagens vd: ”Ingen lyssnade när vi varnade”
Till dags dato har det inte kommit ett enda seriöst, genomtänkt förslag om att göra det enklare och billigare att producera livsmedel, framför Livsmedelsföretagens vd Björn Hellman i sin krönika.
-

Byter bandschaktare mot butik: Största skillnaden är tempot
Från att sälja entreprenadmaskiner till att sälja mat. Det kan synas vara ett långt steg, men för Oskar Carlsson var klivet inte så stort. – Båda jobben handlar om kundmötet, det jag brinner för.
-

Här ska nedlagda Icabutiken återuppstå efter fem år
Först våren 2025 blir det inflyttning för Ica Nära Sätuna i den nya större lokalen. Handlaren Dan Enroth gläds över återkomsten.
-

Kassakaos när City Gross öppnade: ”Angenämt problem”
Köerna ringlade sig långa inför City Gross öppning av den nya butiken i Bromma Blocks. Men stundtals även efter att kunderna välkomnats in.
-

Nybyggda Coop Öjersjö slår äntligen upp portarna
Efter tolv års planering öppnar butiken den 28 oktober.
-

15 års kamp över – här öppnar den nya butiken
Det har varit en lång resa, men nu kan äntligen Ica Supermarket Nykvarn öppna i nya lokaler.
-

Linas Matkasse ska nå fler kunder med fler leveransalternativ
Cheffelo utökar samarbetet med GordonDelivery.
-

Skyddsstoppet hävs – facket kritiskt: ”Bisarrt”
Arbetsmiljöverket godkänner att Orienta åter får öppna butiken. Ett beslut som kritiseras av facket. – Det är bisarrt, säger Martin Nyberg, avtalssekreterare på Handelsanställdas förbund.
-
Ica utforskar svenskodlat kött – ”kan vara på hyllorna om fem år”
Odlat kött har mycket lägre klimatavtryck än vanligt kött. Ica och Re:meat ska ta reda på hur mottaglig konsumenten är, samtidigt startar de ett pilotprojekt för odling.
-

Tvära kast i Icas e-handelsstrategi – cheferna om avvecklingen av lagret i Göteborg
En oväntad marknadsutveckling ligger bakom avvecklingen av Icas e-handelslager i Göteborg. Men trots oklarheter om hur e-handeln ska skötas framöver är ambitionsnivån oförändrad, enligt Ica.